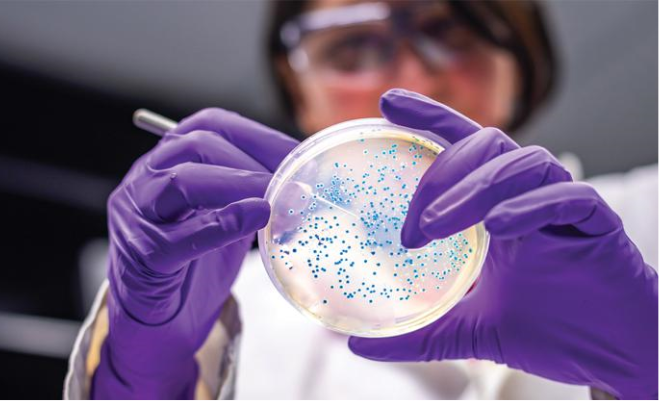

Up to 90% of hospital inpatients receive an IV.3,4 Yet a large number of vascular access devices require multiple placement attempts, or need to be removed early due to complications like central line-associated blood stream infections (CLABSIs), occlusions, phlebitis, infiltration and more.5

Delayed treatment
Increased discomfort and pain
Repeated needlesticks
Vein damage6

Potential drop in confidence8
Additional time spent on
catheter restarts and
placements9

Lower patient satisfaction scores10
Reduced reimbursements and increased penalties11,12
Up to $2,872 to clear occlusions13*
$980,000+ per year in unnecessary PIV restarts5#



Use a needleless system to access IV tubing. […] Ensure that all components of the system are compatible to minimize leaks and breaks in the system.
– Centers for Disease Control and Prevention (CDC)17
Needleless connectors (NC) are considered closed IV connectors. Use needleless connectors as IV connection devices. Avoid three-way stop cocks as IV connections devices.
– International Nosocomial Infection Control Consortium (INICC)18
In general, closed catheter access systems are associated with fewer infections than open systems and should be used preferentially.
– The Joint Commission19

Click on any level to learn more about it

When clinicians and healthcare facility product committees are evaluating medical devices, such as needle-free connectors, for potential adoption/introduction, they should place the greatest weight on real-world, peer-reviewed published clinical evidence that reflects actual clinical practice to inform their decision-making process. Such data are more clinically relevant than vitro laboratory experiments (such as in vitro inoculation studies), which do not include or reflect actual clinical practices.
– William R. Jarvis, MD, President, Jason and Jarvis Associates, LLC
Peer-reviewed
Significant sample size
Clinically demonstrated
The needle-free connector you choose impacts the rate of catheter-related complications in your facility.21,22 Use real-world clinical evidence to help your facility choose the right needle-free connector for every catheter.

Assessment of current infusion practices and products in your facility with actionable recommendations

Needle-free connectors supported by published clinical evidence

Training and education programs to make your clinicians proficient in the latest infusion care practices
* The cost of Alteplase to clear occlusions for every 100 central line days.
# Approximate cost for a 200-bed hospital at an annual estimate for 100,000 catheters, with a 35% failure rate and a conservative $28 average cost per IV insertion.
^ On average cost per patient occurrence.
REFERENCES
1. Zimlichman E, Henderson D, Tamir O, et al. Health care-associated infections A meta-analysis of costs and financial impact on the US health care system. JAMA Intern Med. 2013;173(22):2039–2046. doi:10.1001/jamainternmed.2013.9763
2. Duwadi S, Zhaoa Q, Budal BS. Peripherally inserted central catheters in critically ill patients – complications and its prevention: A review. IJNSS. 2019;6(1):99–105. doi:10.1016/j.ijnss.2018.12.007
3. Alexandrou E, Ray-Barruel G, Carr PJ, et al. International Prevalence of the Use of Peripheral Intravenous Catheters. J Hosp Med. 2015;10(8):530–533. doi: 10.1002/jhm.2389
4. Carr PJ, Rippey JCR, Cooke ML, et al. Development of a clinical prediction rule to improve peripheral intravenous cannulae first attempt success in the emergency department and reduce post insertion failure rates: the Vascular Access Decisions in the Emergency Room (VADER) study protocol. BMJ Open. 2016;6:e009196. doi:10.1136/bmjopen-2015-009196
5. Helm RE, Klausner JD, Klemperer JD, Flint LM, Huang E. Accepted but unacceptable: peripheral IV catheter failure. J Infus Nurs. 2015;38(3):189–203.
6. Hadaway L, Dalton L, Mercanti-Erieg L. Infusion Teams in Acute Care Hospitals Call for a Business Approach: An Infusion Nurses Society White Paper. J Infus Nurs. 2013;36(5):356–360. doi: 10.1097/NAN.0b013e3182a123a9
7. Vital signs: central line-associated blood stream infections. Centers for Disease Control and Prevention (CDC) website. http://www.cdc.gov/vitalsigns/pdf/2011-03-vitalsigns.pdf. Published March 1, 2011. Accessed August 21, 2020.
8. Hunter MR, Vandenhouten C, Raynak A, Owens AK, Thompson J. Addressing the Silence: a Need for Peripheral Intravenous Education in North America. JAVA. 2018;23(3):157–165. doi: 10.1016/j.java.2018.06.001
9. Bausone-Gazda D, Lefaiver CA , Walters SA. A randomized controlled trial to compare the complications of 2 peripheral intravenous catheter-stabilization systems. J Infus Nurs. 2010;33(6):371–384. doi: 10.1097/NAN.0b013e3181f85be2
10. Anderson NR. Influencing Patient Satisfaction Scores: Prospective One-Arm Study of a Novel Intravenous Catheter System With Retractable Coiled-Tip Guidewire Compared With Published Literature for Conventional Peripheral Intravenous Catheters. J Infus Nurs. 2016;39(4):201–209. doi: 10.1097/NAN.0000000000000173.
11. Hospital-Acquired Condition (HAC) Reduction Program. Centers for Medicare & Medicaid Services (CMS) website. http://www.cms.gov/Medicare/Quality-Initiatives-Patient-Assessment-Instruments/Value-Based-Programs/HAC/Hospital-Acquired-Conditions. Updated July 21, 2020. Accessed August 10, 2020.
12. Hospital-Acquired Condition (HAC) Reduction Program. Centers for Medicare & Medicaid Services (CMS) website. http://www.cms.gov/Medicare/Medicare-Fee-for-Service-Payment/AcuteInpatientPPS/HAC-Reduction-Program. Updated February 11, 2020. Accessed August 21, 2020.
13. Williams A. Catheter Occlusion in Home Infusion: The Influence of Needleless Connector Design on Central Catheter Occlusion. J Infus Nurs. 2018;41(1):52–57. doi: 10.1097/NAN.0000000000000259
14. Bouya S, Balouchi A, Rafiemanesh H, et al. Global Prevalence and Device Related Causes of Needle Stick Injuries among Health Care Workers: A Systematic Review and Meta-Analysis. Annals of Global Health. 2020;86(1):351–358. doi: 10.5334/aogh.2698
15. Lee J, Botteman M, Nicklasson L. A Systematic Review of the Economic and Humanistic Burden of Needlestick Injury in the United States. Am J Infect Control. 2004;32(3):E43. doi: 10.1016/j.ajic.2004.04.064
16. Green B, Griffiths EC. Psychiatric consequences of needlestick injury. Occupational Medicine. 2013;63:183–188. doi: 10.1093/occmed/kqt006
17. Guidelines for the Prevention of Intravascular Catheter-Related Infections, 2011. Centers for Disease Control and Prevention (CDC) website. http://www.cdc.gov/hai/pdfs/bsi-guidelines-2011.pdf. Published 2011. Accessed May 5, 2020.
18. INICC International Nosocomial Infection Control Consortium (INICC) Care bundles to prevent central and peripheral line-related bloodstream infections. International Nosocomial Infection Control Consortium (INICC) website. http://www.inicc.org/media/docs/2017-INICCBSIPreventionGuidelines.pdf. Published January 1, 2017. Accessed May 5, 2020.
19. The Joint Commission. Preventing Central Line–Associated Bloodstream Infections: A Global Challenge, A Global Perspective. http://www.jointcommission.org/-/media/tjc/documents/resources/hai/clabsi_monographpdf.pdf. Published May 2012. Accessed June 30, 2020.
20. Ingham-Broomfield R. A nurses’ guide to the hierarchy of research designs and evidence. Aust J Adv Nurs. 2016;33(3):38–43. http://www.ajan.com.au/archive/Vol33/Issue3/5Broomfield.pdf
21. Hadaway L. Needleless Connectors for IV Catheters. Am J Nurs. 2012;112(11):32–44. doi: 10.1097/01.NAJ.0000422253.72836.c1
22. Curran E. Needleless connectors: the vascular access catheter’s microbial gatekeeper. J Infect Prev. 2016;17(5):234–240. doi: 10.1177/1757177416657164
BD is committed to keeping your personal data protected and secure. More information on how we protect your personal data can be found in our privacy statement and our cookie policy.